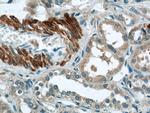
FBXO28 Antibody in Immunohistochemistry (Paraffin) (IHC (P))
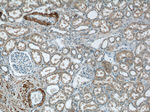
FBXO28 Antibody in Immunohistochemistry (Paraffin) (IHC (P))

Search
Proteintech
FBXO28 Polyclonal Antibody
{{$productOrderCtrl.translations['antibody.pdp.commerceCard.promotion.promotions']}}
{{$productOrderCtrl.translations['antibody.pdp.commerceCard.promotion.viewpromo']}}
{{$productOrderCtrl.translations['antibody.pdp.commerceCard.promotion.promocode']}}: {{promo.promoCode}} {{promo.promoTitle}} {{promo.promoDescription}}. {{$productOrderCtrl.translations['antibody.pdp.commerceCard.promotion.learnmore']}}
产品信息
24282-1-AP
种属反应
宿主/亚型
分类
类型
抗原
偶联物
形式
浓度
规格
纯化类型
保存液
内含物
保存条件
运输条件
产品详细信息
Immunogen sequence: IVAIENILS FMSYDEISQL RLVCKRMDLV CQRMLNQGFL KVERYHNLCQ KQVKAQLPRR ESERRNHSLA RHADILAAVE TRLSLLNMTF MKYVDSNLCC FIPGKVIDEI YRVLRYVNST RAPQRAHEVL QELRDISSMA MEYFDEKIVP ILKRKLPGSD VSGRLMGSPP VPGPSAALTT MQLFSKQNPS RQEVTKLQQQ VKTNGAGVTV LRREISELRT KVQEQQKQLQ DQDQKLLEQT QIIGEQNARL AELERKLREV MESAVGNSSG SGQNEESPRK RKKATEAIDS LRKSKRLRNR K (69-368 aa encoded by BC031576)
靶标信息
Members of the F-box protein family, such as FBXO28, are characterized by an approximately 40-amino acid F-box motif. SCF complexes, formed by SKP1.
仅用于科研。不用于诊断过程。未经明确授权不得转售。
篇参考文献 (0)
生物信息学
蛋白别名: centromere protein 30; F-box only protein 28; unnamed protein product
基因别名: CENP-30; DEE100; Fbx28; FBXO28; KIAA0483
UniProt ID: (Human) Q9NVF7
Entrez Gene ID: (Human) 23219